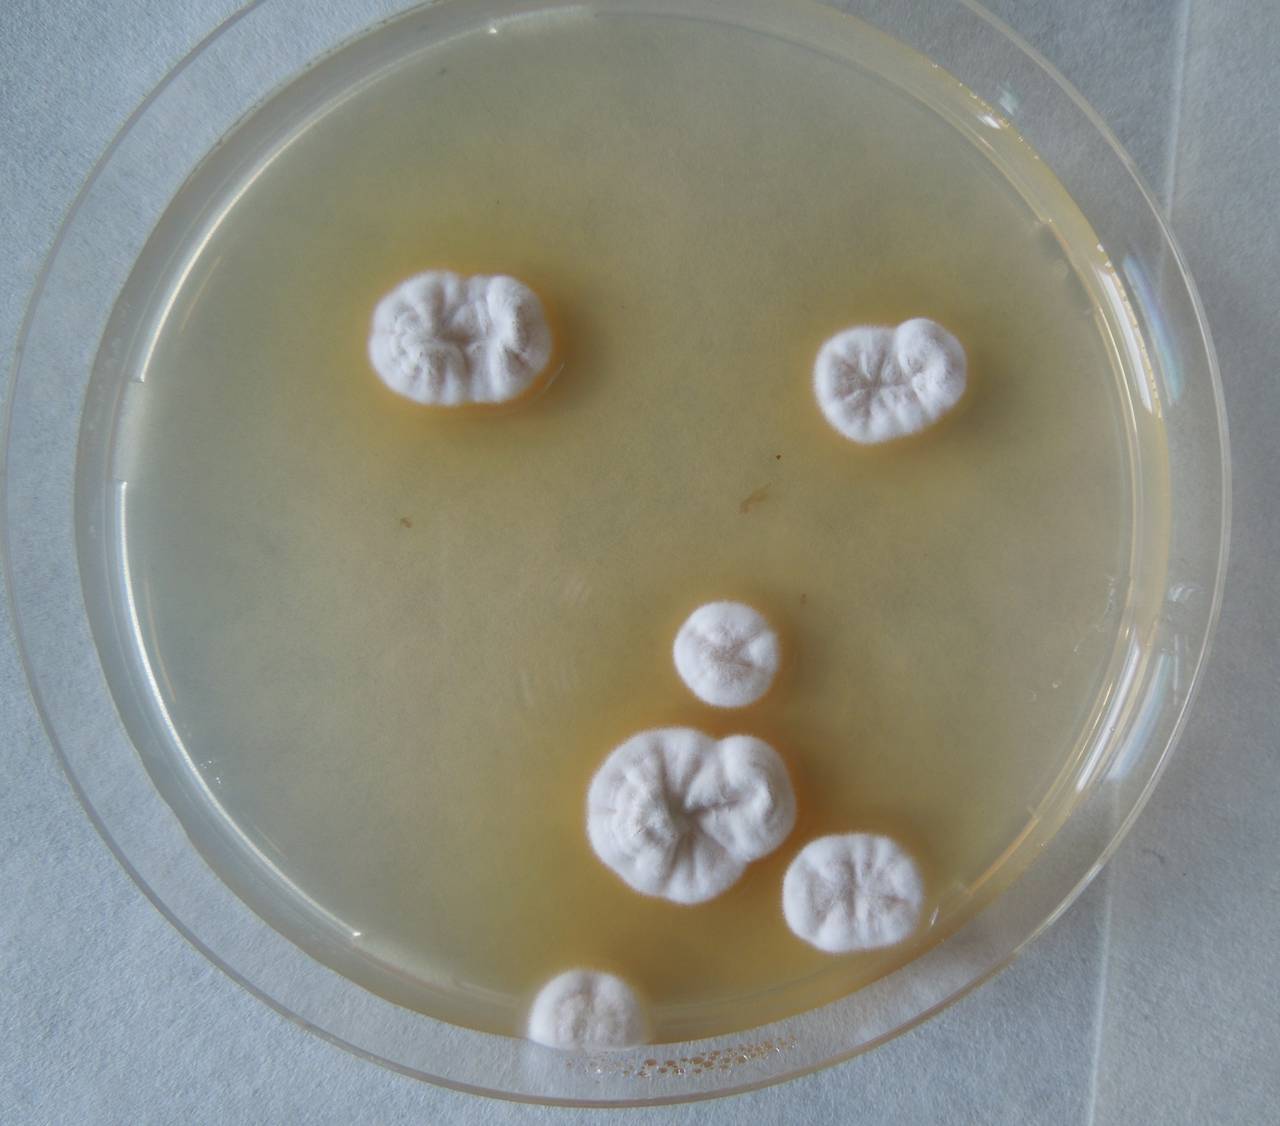
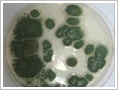

Metarhizium anisopliae
Карта твой кэшбэк отзывы
Унылая пора очей очарованье сколько существительных
Vba excel пробелы
С какого возраста можно в спортзал
Проверить слово удалять
Салат с горбушей консервированной с морковью
Полным с баской
Oscar macro
Гауда российский
Песня туманом не станет
Rexona clinical спрей
С днем свадьбы 44 года совместной
Элицея 5
Metarhizium anisopliae 103 фотографий